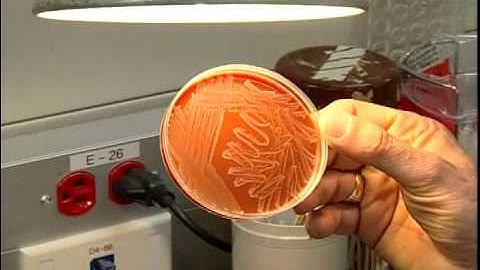
A tour of the Microbiology Lab - Section one

⬇ DOWNLOAD NOW
Kalau muncul iklan pop-up, tutup lalu klik tombol kembali
Download lagu An Orientation to the Microbiology Lab secara gratis hanya untuk keperluan promosi. Dukung artis favorit kamu dengan membeli musik original di iTunes atau platform resmi lainnya.
A tour of the Microbiology Lab - Section one
A tour of the Microbiology Lab - Section one
 MCB2010C Lab: Lab Safety Orientation
MCB2010C Lab: Lab Safety Orientation
 Microbiology Lab for Beginners
Microbiology Lab for Beginners
 A tour of Microbiology Lab (for Freshers)
A tour of Microbiology Lab (for Freshers)
 Orientation to the Microbiology Laboratory
Orientation to the Microbiology Laboratory
 Go Inside a Clinical Microbiology Lab
Go Inside a Clinical Microbiology Lab
 Microbiology Lab Tour & Safety
Microbiology Lab Tour & Safety
 A tour of the Microbiology Lab - Section Two
A tour of the Microbiology Lab - Section Two